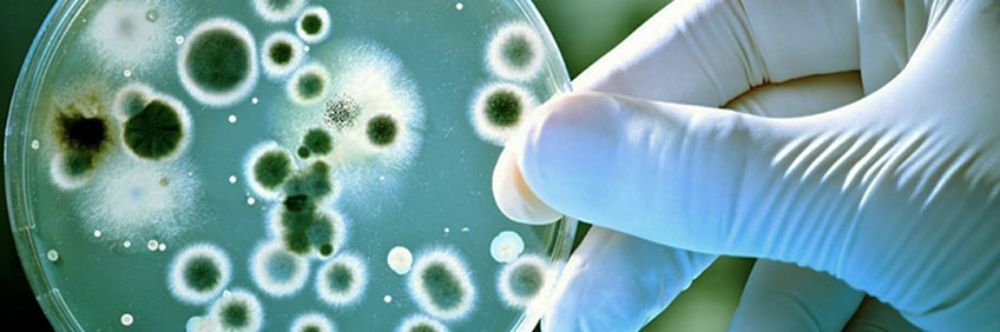
Ingeniería en Biotecnología Molecular

Ingeniería en Biotecnología Molecular
- Grado Académico
- Licenciado/a en Ingeniería en Biotecnología Molecular
- Título profesional
- Ingeniero/a en Biotecnología Molecular
- Nº de Decreto
- D.U. N° 0039852 del 24 de octubre de 2017
- Facultad o Instituto
- Facultad de Ciencias
- Duración
- 10 semestres lectivos, jornada diurna, con currículum semiflexible
Carrera dirigida a jóvenes con un alto interés por una disciplina rigurosa y exigente en lo científico. Su objetivo es preparar un profesional capaz de integrar conocimientos básicos con la problemática de la biotecnología, y así insertar la ciencia en los aspectos productivos. Sus áreas de desarrollo se ubican en la biotecnología ambiental e industrial; biotecnología en minería y recursos marinos.
Campo laboral: Esta especialidad de la ingeniería tiene una importante proyección profesional futura. Los titulados pueden desempeñarse en sectores públicos, privados e internacionales, en las áreas de agricultura, pesca, industria alimenticia, minera, farmacéutica, entre otros. Además, pueden optar por la investigación en centros de avanzada en ingeniería genética y biomedicina.
Admisión
Proceso de Admisión Regular 2026:
| Código de postulación: | 11039 |
| Vacantes 2026: | 35 |
| Revisa los requisitos generales de postulación a la Universidad de Chile. | |
Requisitos y ponderaciones Admisión 2026:
| Notas de Enseñanza Media | 10% |
| Ránking de Notas | 20% |
| Prueba PAES de Competencia Lectora | 20% |
| Prueba PAES de Competencia Matemática 1 | 10% |
| Prueba PAES de Competencia Matemática 2 | 15% |
| Prueba PAES de Ciencias | 25% |
Procesos de Admisión Especial 2026:
| Vacantes BEA (ver más) | 5 |
| Vacantes SIPEE (ver más) | 1 |
| Vacantes PACE (ver más) | 2 |
| Vacantes Ed. Media en el Extranjero (ver más) | 3 |
| Vacantes para Deportistas Destacados/as (ver más) | 2 |
| Vacantes para Est. de Pueblos Indígenas (ver más) | 3 |
| Vacantes para Est. Sit. de Discapacidad (ver más) | 2 |
| Vacantes Cupos Explora-UNESCO (ver más) | 1 |
Síntesis del Perfil de Egreso
El (la) Ingeniero(a) en Biotecnología Molecular (IBM) titulado(a) de la Universidad de Chile es un profesional experto en la comprensión y optimización de procesos biológicos desde un enfoque genético, molecular y sistémico, para producir nuevo conocimiento y generar productos y servicios de alto valor.
Este profesional es capaz de reconocer problemáticas biológicas, desarrollar, implementar, administrar y comunicar soluciones biotecnológicas innovadoras, basadas en la investigación científica, en diversos sectores académicos y productivos desarrollando su quehacer con un alto compromiso ético para preservar el medio ambiente, fomentar la equidad social y apoyar el desarrollo científico-tecnológico del país.
El IBM desarrolla procesos de innovación, investigación y comunicación, con una perspectiva crítica y autocrítica, desenvolviéndose de manera proactiva, en forma independiente o integrando equipos interdisciplinarios en los ámbitos público y/o privado.
Plan de Formación
Primer Año |
|||
Semestre I |
|||
| Asignaturas y Actividades Curriculares |
Área de Formación
|
Horas directas teóricas
|
Créditos SCT
|
| MATEMÁTICAS I | Básica | 4,5 | 8 |
| QUÍMICA GENERAL I | Básica | 3,0 | 8 |
| BIOLOGÍA CELULAR | Básica | 3,0 | 7 |
| ZOOLOGÍA | Básica | 3,0 | 7 |
Semestre II |
|||
| Asignaturas y Actividades Curriculares |
Área de Formación
|
Horas directas teóricas
|
Créditos SCT
|
| MATEMÁTICAS II | Básica | 4,5 | 8 |
| QUÍMICA GENERAL II | Básica | 3,0 | 8 |
| INTRODUCCIÓN A LA MECÁNICA | Básica | 3,0 | 7 |
| BIOLOGÍA VEGETAL | Básica | 3,0 | 7 |
Segundo Año |
|||
Semestre III |
|||
| Asignaturas y Actividades Curriculares |
Área de Formación
|
Horas directas teóricas
|
Créditos SCT
|
| ÁLGEBRA LINEAL Y CÁLCULO VECTORIAL | Básica | 4,5 | 8 |
| ÓPTICA Y ELECTROMAGNETISMO | Básica | 3,0 | 7 |
| QUÍMICA ORGÁNICA | Básica | 4,5 | 9 |
| INTRODUCCIÓN A LA INGENIERÍA GENÉTICA | Básica | 3,0 | 3 |
| ACUICULTURA | Especializada | 3,0 | 3 |
Semestre IV |
|||
| Asignaturas y Actividades Curriculares |
Área de Formación
|
Horas directas teóricas
|
Créditos SCT
|
| MÉTODOS Y APLICACIONES DE LAS ECUACIONES DIFERENCIALES | Básica | 3,0 | 8 |
| BIOQUÍMICA | Básica | 4,5 | 9 |
| TERMODINÁMICA | Básica | 3,0 | 8 |
| INGLÉS CIENTÍFICO I | Complementaria | 3,0 | 3 |
| CURSO DE FORMACIÓN GENERAL I | General | 3,0 | 2 |
Tercer Año |
|||
Semestre V |
|||
| Asignaturas y Actividades Curriculares |
Área de Formación
|
Horas directas teóricas
|
Créditos SCT
|
| GENÉTICA | Especializada | 4.5 | 8 |
| MICROBIOLOGÍA | Especializada | 4.5 | 8 |
| BIOESTADÍSTICA | Básica | 3.0 | 6 |
| CINÉTICA Y ELECTROQUÍMICA | Básica | 3.0 | 8 |
Semestre VI |
|||
| Asignaturas y Actividades Curriculares |
Área de Formación
|
Horas directas teóricas
|
Créditos SCT
|
| BIOLOGÍA MOLECULAR | Especializada | 4,5 | 7 |
| FISICOQUÍMICA MACROMOLECULAR | Especializada | 4,5 | 7 |
| TALLER DE INGENIERÍA GENÉTICA | Especializada | 1,5 | 8 |
| ELECTIVO ESPECIALIDAD O UNIDAD DE INVESTIGACIÓN ELECTIVA | Especializada | 3,0 | 6 |
| CURSO DE FORMACIÓN GENERAL II | General | 3,0 | 2 |
Cuarto Año |
|||
Semestre VII |
|||
| Asignaturas y Actividades Curriculares |
Área de Formación
|
Horas directas teóricas
|
Créditos SCT
|
| BIOTECNOLOGÍA | Especializada | 3,0 | 6 |
| INSTRUMENTACIÓN | Especializada | 3,0 | 7 |
| FISIOLOGÍA GENERAL | Especializada | 4,5 | 8 |
| ECOLOGÍA MICROBIANA Y BIOTECNOLOGÍA AMBIENTAL | Especializada | 4,5 | 6 |
| INGLÉS CIENTÍFICO II | Complementaria | 3,0 | 3 |
Semestre VIII |
|||
| Asignaturas y Actividades Curriculares |
Área de Formación
|
Horas directas teóricas
|
Créditos SCT
|
| INMUNOLOGÍA | Especializada | 3,0 | 6 |
| MICROECONOMÍA | Especializada | 3,0 | 5 |
| FISIOLOGÍA VEGETAL | Especializada | 3,0 | 7 |
| OPTIMIZACIÓN | Especializada | 4,5 | 6 |
| BIOÉTICA | Básica | 1,5 | 3 |
| PATENTES Y LEGISLACIÓN | Especializada | 3.0 | 3 |
CICLO PROFESIONAL |
|||
Quinto Año |
|||
Semestre IX |
|||
| Asignaturas y Actividades Curriculares |
Área de Formación
|
Horas directas teóricas
|
Créditos SCT
|
| MICROBIOLOGÍA INDUSTRIAL | Especializada | 3,0 | 5 |
| BIOTECNOLOGÍA MÉDICA | Especializada | 3,0 | 5 |
| OPERACIONES UNITARIAS | Especializada | 3,0 | 8 |
| TALLER DE BIOTECNOLOGÍA VEGETAL | Especializada | 2,0 | 5 |
| UNIDAD DE INVESTIGACIÓN DE SEMINARIO DE TITULO | Especializada | - | 7 |
Semestre X |
|||
| Asignaturas y Actividades Curriculares |
Área de Formación
|
Horas directas teóricas
|
Créditos SCT
|
| EVALUACIÓN DE PROYECTOS | Especializada | 3,0 | 4 |
| SEMINARIO DE TÍTULO | Especializada | 1,0 | 26 |
Departamento de Pregrado
Vicerrectoría de Asuntos Académicos